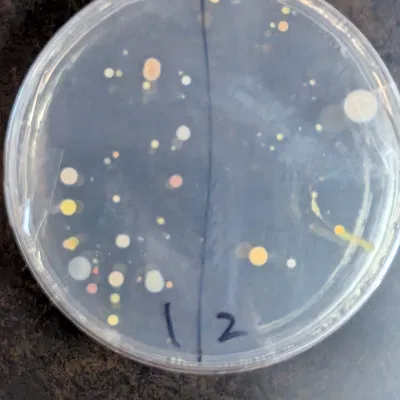
Tops Our Fun

@hayden_4349096
Mô Hình
2
Người Theo Dõi
0
Lượt Thích
Lượt Xem
Pát Treo Tường Camera UniFi Protect AI 360
bởi hayden_4349096
Pát treo tường cho UniFi Protect AI 360 (tương thích cả G4 Dome), dùng được tron
834
8
147
Tops Our Fun
bởi hayden_4349096
Mẫu 3D “tops our fun” với mô tả ngắn gọn là “top”. Nội dung hiện tại khá tối giả
30
0
0
Đang tải models...




